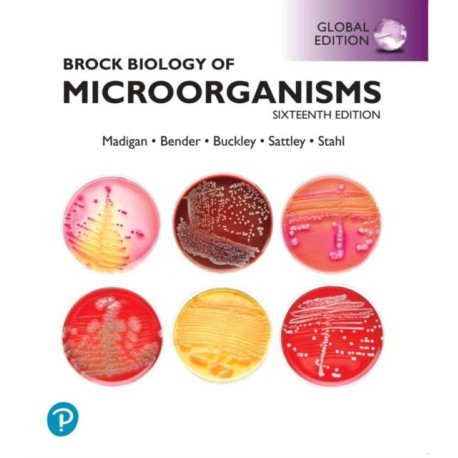
Brock Biology of Microorganisms Biology, Global Edition + Mastering Biology with Pearson eText (Package)

Kurv
Vare
varer
(tom)
Ingen varer
Fastlægges senere
Forsendelse
0,- kr
I alt
Brock Biology of Microorganisms Biology, Global Edition + Mastering Biology with Pearson eText (Package)
(Engelsk)
Forlag:
Pearson Education Limited
- Format: Multiple-component retail product
-
Sprog:
Engelsk

- ISBN-13: 9781292405230
- Se flere detaljer ▼
Bemærk: Kan ikke leveres før jul.
Læsernes anmeldelser (0)
Alle detaljer
| Forlag | Pearson Education Limited |
| Forfattere | Michael Madigan, Jennifer Aiyer, Daniel Buckley, W. Sattley, David Stahl |
| Format | Multiple-component retail product |
| Sprog | Engelsk |
| Udgave | 16 ed |
| Udgivelsesdato | 17-09-2021 |
| Første udgivelsesår | 2021 |
| Originalsprog | United Kingdom |
| Indbinding | Multiple-component retail product |
| Forlag | Pearson Education Limited |
| Mål | 269 x 291 x 47 |
| ISBN-13 / EAN-13 | 9781292405230 |

